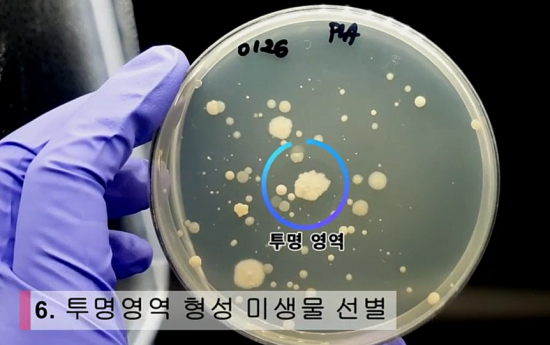

'평소 3배' 추석 쓰레기..양심에 찔리십니까?[과학을읽다]
철저한 분리배출이 첫 걸음.."수도권 주민들, 2025년 매립지 종료 감안 더 시급"
![[이미지출처=연합뉴스]](https://img4.daumcdn.net/thumb/R658x0.q70/?fname=https://t1.daumcdn.net/news/202109/20/akn/20210920084246437pyej.jpg)
[아시아경제 김봉수 기자] 태평양에 거대한 플라스틱 섬이 떠돌고, 동물들이 죽어갑니다. 잘게 부서져 떠도는 미세플라스틱은 시한폭탄처럼 인류를 위협하고 있죠. 추석을 맞아 가정마다 배달된 선물 꾸러미들에게서도 포장재 등 엄청난 플라스틱 쓰레기들이 배출됩니다. 코로나19로 배달 음식과 온라인 쇼핑이 20~30%씩 늘어났고, 1회용 컵을 즐겨 쓰는 커피문화가 확산되는 등 업친 데 덮친 격입니다.
약 100년 전 스타우딩거가 고분자(폴리머)의 개념을 처음 제시하면서 플라스틱 시대가 본격 개막됐을 때만 해도 이런 부작용을 생각했을까요? 당시만 해도 플라스틱 등 고분자 물질의 발견은 신문명을 창출한 위대한 업적이었습니다만, 이젠 너무 견고한 화학 구조라는 장점이 오히려 엄청난 환경 오염을 초래하는 단점으로 부각되고 있습니다. 과연 플라스틱을 만들어 낸 인류의 과학기술은 그 부작용의 해법도 만들어 낼 수 있을까요?
![[이미지출처=연합뉴스]](https://img1.daumcdn.net/thumb/R658x0.q70/?fname=https://t1.daumcdn.net/news/202109/20/akn/20210920084247637dofi.jpg)
◇ 폐비닐 쓰레기산을 없앤다
폐플라스틱 문제를 해결하는 것은 자원화 등 재활용과 분해 미생물 활용, 생분해성 수지 사용 등 3가지 방법이 연구되고 있습니다. 우선 한국에서 10여년 전부터 시작된 폐비닐 자원화 기술은 발전을 거듭하고 있습니다. 현재의 기술로는 에너지가 많이 드는 반면 생산되는 오일의 양은 적습니다. 1일 1회만 운전이 가능하고 가열과 냉각을 반복해 에너지 손실이 큽니다. 설비 수명도 짧고 오일 수율도 30~40%에 그치죠. 폐비닐 자원화가 본격화되기엔 아직 부족한 수준입니다.
한국에너지기술연구원 이경환 박사 연구팀이 지난 2월 발표한 신기술에 관심이 쏠리는 이유입니다. 이 박사팀은 적은 에너지로 오일은 두 배 가량 더 뽑아 내는 기술을 개발했습니다. 원료 투입 및 잔사물 배출을 위해 기계를 껐다가 켜는 불편이 없이 계속 운전이 가능합니다. 낮은 에너지를 사용하는 일정한 반응 온도에서 오일을 안정적으로 생산하고 수율도 62%로 높습니다. 연구원은 이 기술을 현재 상업용 생산을 위한 스케일업(용량 확대) 연구 중이며, 2022년엔 1일 10t 처리가 가능하도록 해 상업화한다는 방침입니다. 우리가 쓰고 버리는 폐비닐은 연간 200만t 이상이며, 이중 70~80%는 그냥 소각ㆍ매장되거나 버려져 환경 오염을 일으키고 있습니다. 2019년 경북 의성 쓰레기산 사건이 대표적 사례죠. 강원, 인천 등의 일부 지자체에선 이미 폐비닐 자원화를 통해 쓰레기도 처리하고 자원도 확보하는 수확을 거두고 있습니다.

◇ 분해 미생물을 찾아라
플라스틱 문제를 해결하기 위한 또 다른 수단은 자연계에서 플라스틱을 '먹어 치우는' 미생물을 찾는 연구입니다. "그런 게 있겠냐"는 의문이 들 수도 있지만 실제 있습니다. 최근 오스트리아 산업생명공학센터(ACIB)는 플라스틱을 분해하는 미생물을 소 위에서 찾았다고 발표했습니다. 소 반추위에 서식하는 미생물이 페트병과 섬유에 쓰이는 합성 폴리에스터 성분인 폴리에틸렌 테레프타레이트(PET)를 분해하는 것을 발견했다는 겁니다. 지난해 6월 김대환 대구경북과학기술원(DGIST) 교수 연구팀이 아메리카왕거저리 유충인 '슈퍼웜' 체내 장액에서 플라스틱 소재인 폴리스틸렌을 분해하는 사실을 발견한 사례도 있다.
이처럼 과학계에서는 플라스틱 분해 미생물을 찾으려는 노력에 박차를 가하고 있습니다. 자연계에 존재하는 미생물 중 인간이 기능을 알고 있는 것은 10% 정도에 불과하고 나머지 90%는 파악하지 못하고 있죠. 최근 한국화학연구원이 1주일 내에 미생물의 플라스틱 분해 여부를 파악할 수 있는 스크리닝 키트를 개발한 것도 그 같은 노력의 일환이죠.
미생물을 이용한 플라스틱 분해는 미생물 대량 생산 공정과 유통ㆍ공급 등의 시스템이 갖춰져야 해 아직까지 상용화는 어렵습니다. 그러나 날이 갈수록 플라스틱 공해가 심해지고 기후 변화가 심각해지고 있어 향후 활용 가능성이 높습니다. 화학연구원에 따르면, 해외 국가들은 플라스틱 분해 미생물 리스트를 외부에 공개하지 않고 국가적 자산으로 간주해 극비리에 보관하고 있다고 합니다.
◇ 썩는 플라스틱을 만들자
아예 플라스틱 자체를 '생분해성' 소재로 만들자는 움직임도 가속화되고 있습니다. LG화학이 최근 충남 대산공장에 2조6000억원을 투자해 생산 설비를 지으면서 생분해성 수지 등 친환경 소재를 만들겠다고 나선 것이 대표적 사례입니다. SKC도 지난 16일 일본기업과 함께 쉽게 분해되는 플라스틱소재를 개발하겠다고 발표했습니다. 요즘은 기업들도 수출 등 생존을 위해 ESG(환경ㆍ사회ㆍ지배구조)를 생각하는 경영과 기술 개발이 필수인 시대죠.
국가 차원의 첨단 기술 개발도 계속되고 있습니다. 한국화학연구원의 오동엽 박사 연구팀은 최근 땅 속에서 100% 생분해되는 데 6개월이 걸리는 비닐봉투를 개발했습니다. 여러 목적에 따라 다른 특성을 지닌 바이오플라스틱(PBS)으로 만들었습니다. 제작 비용도 저렴하고 다른 생분해성 비닐봉투와 달리 잘 찢어지지도 않습니다. 목재펄프와 게 껍질에서 각각 추출한 셀룰로오스와 키토산을 첨가해 인장 강도가 두 배 강합니다. 옷이나 신발 등 다른 물질로도 가공됩니다.
플라스틱 문제는 먼 이야기가 아닙니다. 당장 수도권 주민들은 2025년 수도권 매립지 사용 종료에 따라 플라스틱ㆍ비닐 쓰레기 문제를 최우선적으로 해결해야 할 처지입니다. 당장 추석 연휴가 끝난 후 재활용 쓰레기 분류를 철저히 하는 것부터 시작하면 어떨까요?
김봉수 기자 bskim@asiae.co.kr
Copyright © 아시아경제. 무단전재 및 재배포 금지.
- 삼전·하닉에 결혼자금 3억 몰빵 투자한 공무원…결말은? - 아시아경제
- 벌써 '20만 장' 팔렸다…"단돈 8천원에 순금 갖는다" Z세대 '깜짝' 인기 - 아시아경제
- "5시간 갇혀 화장실도 못 가" 야경 보러 간 20명 日 스카이트리서 '날벼락' - 아시아경제
- '약물 사자와 한 컷?' 논란에…노홍철 "낮잠 시간이라 안전" 해명 - 아시아경제
- '운명전쟁49', 순직 경찰·소방관 모독 논란에 결국 "재편집 결정" - 아시아경제
- "아내가 바람 피워" 집에 불지른 男…300채 태운 대형 참사로 - 아시아경제
- "이젠 개도 PT 받는다"…한달 42만원, 상하이에 펫전용 헬스장 등장 - 아시아경제
- "철밥통 옛말됐다" 충주맨 이어 공직사회 번지는 '조기 퇴직' - 아시아경제
- 전원주, 카페 '3인 1잔' 논란에…제작진 "스태프 전원 주문" 해명 - 아시아경제
- 아기 3명 숨졌다…"모유랑 똑같이 만든다더니 '독소' 범벅" 분유 정체 - 아시아경제